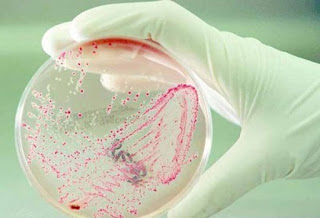

La falta de productos de alimentación que no llegan al consumidor venezolano es consecuencia de la continúa guerra económica, lo cual ha generado la plaga de bachaqueros que arrasa con todo para vender a precios especulativos y no permitir a madres y padres de escasos recursos económicos adquirir los alimentos para sus hijos.
"Ya no sólo cuesta conseguir la comida en los supermercados sino que la que llega siempre están los bachaqueros de por medio y ellos e llevan todo. He visto como los bachaqueros hacen una cola meten a su combo de personas y luego salen a revender en la misma cola lo que compró a precio justo con precio exorbitantes. Por ejemplo un arroz de 500 bolívares lo quieren vender de 2500 a 3000 bolívares", acotó Jesús Alfonzo habitante de la parroquia El Valle.
Sumado a ello, los bachaqueros pasan desapercibidos ante la Guardia Nacional, policías y otros funcionarios pues a veces no se sabe quién es el que vende los productos de alimentación, inclusive en la vía pública y con la mayor impunidad.
"He tenido que comprar a los bachaqueros por necesidad ya que no consigo nada. He visto diferentes precios y que venden hasta por bultos; por ejemplo ahorita venden los bultos de harina sea cual sea la marca desde 40 mil hasta 47 mil bolívares", agregó Mary Valcarcel de la parroquia Coche.
Otro factor que afecta son las inmensas colas que se hacen todos los días en diversos supermercados o negocios que expenden productos regulados y ahora se le suman las colas que también se hacen en las panadería.
"Ahorita en la panadería donde vivo tienen el pan campesino en 500 bolívares, sin contar las colas que se hacen en diferentes horas y los números que reparten para saber hasta donde pueden ver. Todo esto es un abuso y los entes correspondientes deben tomar cartas en el asunto", agregó Inés Ramírez, habitante de Guatire.
Por tal motivo el Sundee coloca a disposición los siguientes números para denunciar al comerciante usurero, acaparador, bachaquero: 0212 3773528, 0212 3773707, 0212 3776587, 0212 3776453, 0212 3776437 o Denuncia al Especulador 0800 5658786.
Es importante saber que para denunciar se requiere:
- Tener a la mano los siguientes datos: Estado/ municipio / parroquia/ avenida/ calle/ nombre del sector/ punto de referencia/ nombre de la panadería.
Síguenos a través de nuestro pin: 7AB2154D y el twitter@elparroquiano
Si deseas comunicarte con nosotros ya sea para denunciar, aportar o publicitar con nosotros, escríbenos acá: eparroquiano5@gmail.com